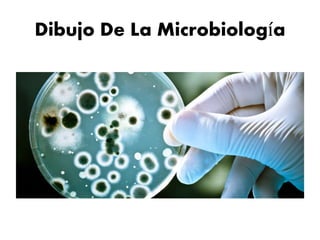
Dibujo De La Microbiología

La microbiología estudia organismos microscópicos como bacterias y hongos. Analiza sus características de cultivo, morfológicas y metabólicas. Aunque se conocían sus propiedades curativas desde la antigüedad, la microbiología emergió como ciencia a finales del siglo XIX, impulsada por los primeros avistamientos microscópicos de Van Leeuwenhoek en el siglo XVII.